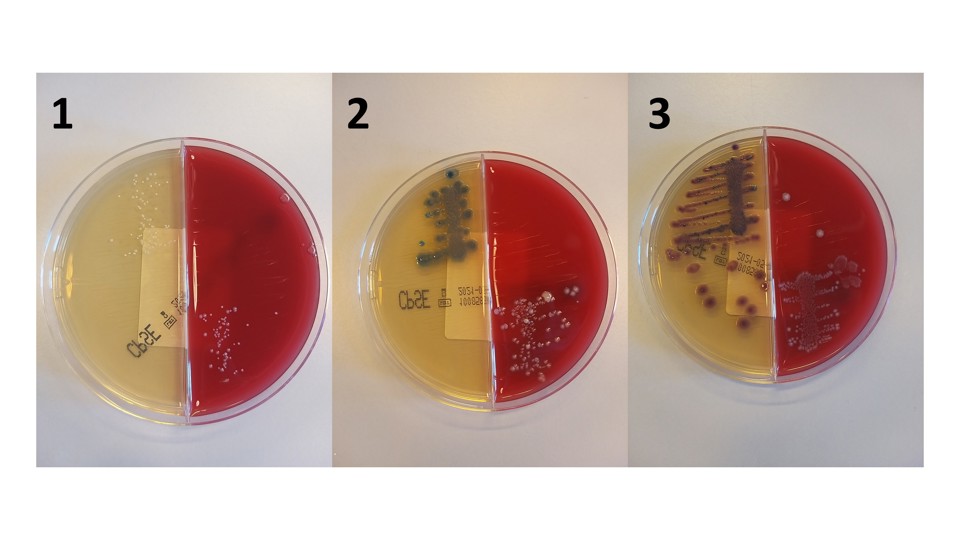
Urindyrkning

Diagnostik og udredning
Her beskriver vi hvordan blærebetændelse udredes og diagnosticeres.
Vejen gennem udredning
Hvis du har mistanke om en urinvejsinfektion skal du kontakte egen læge. Lægen er det første skridt mod en diagnose.
Diagnosen "Blærebetændelse" stilles på baggrund af to kriterier:
1. Symptomer på blærebetændelse
2. Påvisning af mikroorganismer i urinen
Man har altså kun blærebetændelse, hvis man opfylder begge af ovenstående kriterier. Har man alene bakterier i urinen og ikke ledsagende symptomer fra urinvejene, så har man den tilstand der kaldes asymptomatisk bakteriuri, som ikke skal behandles. Det modsatte gør sig også gældende, at hvis man har symptomer, men ikke kan påvise bakterier i urinen, jamen så har man heller ikke blærebetændelse og skal derfor ikke behandles – i hvert fald ikke med antibiotika.
Symptomerne kan man mundtlig berette til sin læge, men for at påvise bakterier er man nødt til at lave en urindyrkning. Dette foretages fra en urinprøve. Den korrekte måde at opsamle urin er som en ren midtstråleurin, og gøres på følgende måde:

Link: Midtstråleurin til dyrkning
Med tilladelse fra Afdeling for Klinisk Mikrobiologi - Herlev og Gentofte Hospital
Urindyrkningen er det helt grundlæggende værktøj til at påvise bakterier i urinen. Vi bruger urindyrkningen til at besvare tre spørgsmål:
Hvilken bakterie er til stede?
Hvor mange bakterier er der?
Hvad kan bakterierne behandles med? (resistensbestemmelse)
Det første spørgsmål handler om at finde ud af hvilken eller hvilke bakterier der er til stede. Det er der flere gode grunde til. Ofte når man tager en urinprøve så vil der komme forureningsbakterier med i prøven, dvs. bakterier bor som på huden eller i skeden, f.eks. det der hedder lactobaciller, som er en slags mælkesyrebaktiere. Det er altså vigtigt for os at kunne sige om bakterierne i urinprøven er ufarlige forureningsbakterier eller sygdomsfremkaldende bakterier som fx kolibakterier. Dette understreger også vigtigheden af at være omhyggelig når man opsamler sin urinprøve til lægen.
Det er vigtigt, at man opsamler den urin der kaldes ’midtstråleurin’. For at gøre det lader man først vandet i toilettet i et par sekunder for at skylle ’det værste snavs’ ud af urinrøret og herefter opsamler man sin urinprøve i et rent opsamlingsbæger. Til sidst tømmer man blæren helt i toilettet. Ved denne metode minimeres antallet af forureningsbakterier. Selv om man er meget omhyggeligt er det svært helt at undgå, at forurene sin urinprøve - dette leder os til næste spørgsmål.
Det andet spørgsmål handler om at tælle hvor mange bakterier der er til stede. Kolibakterier og andre bakterier som giver blærebetændelse trives utroligt godt i urin og én enkelt kolibakterie kan formere sig og blive til 16 millioner bakterier inden for en almindelig arbejdsdag – husk derfor at lade vandet jævnligt! Dette betyder, at hvis man har en blærebetændelse så vil vi sort set altid se et meget højt antal af bakterier ved urindyrkningen. Hvis vi kun ser ganske få bakterier (under 10 bakterier pr milliliter) så tyder det på at der er tale om forurening. Mange af de klassiske bakterier som kan give blærebetændelse fx kolibakterier og klebsiella bor i tarmen og bevæger sig ud på huden på ballerne, mellemkødet og i skeden og kan derfor sagtens optræde som forurening i en urinprøve.
En urindyrkning med kolibakterier kan være tegn på blærebetændelse, men det kan også være tegn på en forurening ved prøvetagningen. Det er derfor ikke altid helt nemt at diagnosticere blærebetændelse.
Urinen udsåes på en agarplade som er delt op i to felter: almindelig agar (CPSE) og blodagar (den røde). Nogle bakterier gror bedst, når der er blod til stede i dyrkningsmediet. Herefter inkuberes pladen i varmeskab i ca. 16 timer. Bakterierne kan gro frem med forskellige farver. Røde kolonier er oftest kolibakterier (t.h.). Klebsiella pneumoniae bliver grøn (i midten).
Resistensbestemmelse
Hvis en patient har symptomer på blærebetændelse og vi kan påvise et højt antal bakterier i urinen så skal vedkommende behandles. Der findes mange forskellige bakterier og ikke alle bakterier kan behandles ens. Selv inden for samme bakterieart, f.eks. kolibakterier er der ofte stor forskel på behandlingsmetode. Hvis en bakterie bliver hæmmet eller slået ihjel af antibiotika, kaldes bakterien følsom, hvis den derimod ikke bliver slået ihjel kaldes bakterien resistent. Hvis der findes bakterier i urinen, laves der altid resistensbestemmelse for at finde ud af, hvilke antibiotikatyper der kan behandles med.
En udbredt misforståelse er, at patienter kan blive resistente over for antibiotika. Dette er helt forkert. Mennesker er altid resistente overfor antibiotika og er født sådan – ellers ville vi dø hver gang vi fik antibiotika. Det er kun bakterier som er følsomme for antibiotika, der kan blive resistente.
Mikroskopi
Ved mikroskopi af urin kan man se bakterier som sorte prikker eller stave. Man kan bruge mikroskopi til at lave et foreløbigt skøn om hvor mange bakterier der er i urinen. Undersøgelsen er bedst til at udelukke blærebetændelse i det tilfælde, hvor man ikke ser bakterier i patientens urinprøve.
Mikroskopi af urin bruges ikke på hospitalerne. Til gengæld bruges mikroskopi nogle gange hos din egen læge til at lave en hurtig og foreløbig vurdering af om behandling skal startes op eller om man kan afvente et dyrkningssvar som oftest tager 1-2 døgn.
Egen lægen vil starte udredning hvis man oplever gentagende urinvejsinfektioner (rUVI). Til det anvendes et tre dages væske-vandladningsskema (VVS), screening for risikofaktorer og forbyggende minimal care.
Læs mere om VVS her
Din egen læge kan efterfølgende henvise til Urinvejskirurgisk afdeling for yderligere udredning og behandling.
Før besøget:
- Væskevandladningsskema (VVS) udfyldes over 3 dage.
- Hvis der er inkontinens/urin utæthed laves ligeledes bindvejningstest.
- Symptomskemaer udfyldes.
Besøg i ambulatoriet (1-2 besøg):
- Flow (vandladningsundersøgelse): patienten lader vandet i et flowmeter (måletoilet). Herved fremstilles patientens vandladning i en flowkurve, som giver oplysninger om bl.a. urinstrålens hastighed og blæretømningstiden
- Residualurin: Måling af resturin vha ultralyd blærescanning efter vandladning.
- Sygehistorie gennemgang
- Gennemgang af medicin
- Risikofaktorer gennemgås (se tabel 2 nedenfor)
- Urindyrkninger gennemgås
- Gennemgang af flow og resturinmåling, VVS og bindvejningstest
- Objektiv undersøgelse – mave, blære og nyre mærkes. Kønsorganger efterses.
- MÆND: palpation af prostata, Ultralyd scanning af prostata (TRUS)
- KVINDER: gynækologisk undersøgelse (vurdering fra egen læge eller gynækolog kan anvendes)
- Eventuelt cystoskopi (blærekikkertundersøgelse) og CT-scanning af nyrer
- Samtale med tolkning af undersøgelsesresultater
Tjek video om forberedelse og ambulant besøg
Eksempler på vandladningskurver fra flow undersøgelse:
